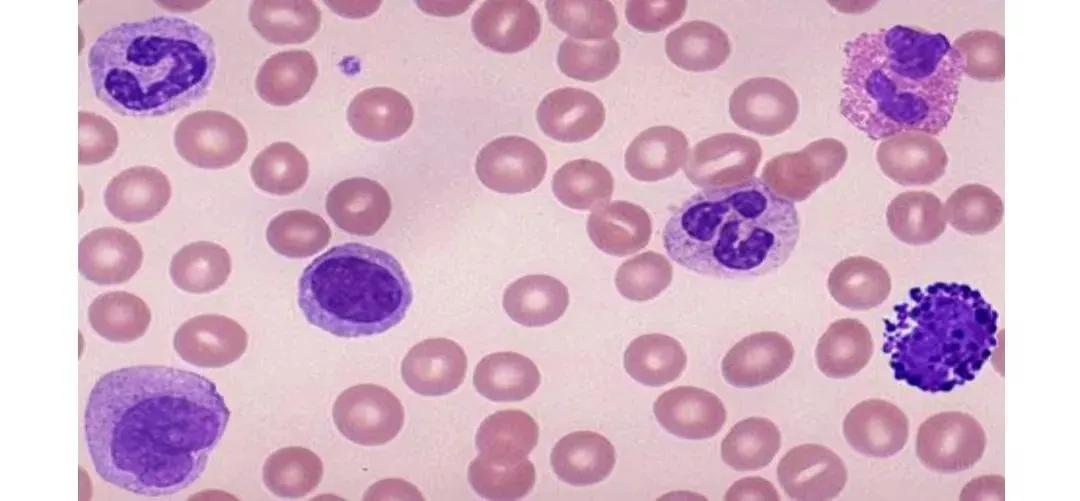
Image

白细胞增多临床意义总结
发布时间:2024-09-02

白细胞计数超过11000个细胞/微升(11×10^9个细胞/升)被称为白细胞增多。这个指标看似简单,却蕴含着丰富的临床意义,可能预示着多种健康问题。
白细胞增多的原因多种多样。生理因素包括月经期、妊娠、分娩、哺乳期,以及剧烈运动、高温严寒等。例如,孕妇的白细胞计数可能高达15×10^9/L。药物因素也不容忽视,糖皮质激素、红霉素、头孢类等药物都可能导致白细胞升高。
然而,白细胞增多更常见于病理状态。感染是最常见的原因,无论是细菌、病毒、真菌还是寄生虫感染,都可能引发白细胞增多。例如,慢性粒细胞白血病患者的白细胞总数可能高达100~600×10^9/L。其他可能导致白细胞增多的疾病还包括骨髓纤维化、真性红细胞增多症、类风湿关节炎、结核病等。
值得注意的是,白细胞增多并不总是意味着严重问题。在应激状态下,如大手术后、烧伤、急性创伤性大出血等,白细胞计数可能暂时升高,但通常不会超过20×10^9/L。这种情况下,白细胞增多反而可能对机体起到保护作用。
治疗白细胞增多需要针对原发病进行。例如,对于由感染引起的白细胞增多,可能需要使用抗生素或抗病毒药物。对于某些特定疾病,如单核细胞增多症,可能没有专门的治疗方法,主要依靠休息和对症治疗。在某些情况下,如严重的呼吸道狭窄,可能需要使用皮质类固醇治疗。
然而,我们也要认识到白细胞计数作为诊断工具的局限性。正如中国医药教育协会感染疾病专业委员会在《感染相关生物标志物临床意义解读专家共识》中指出的,目前还没有任何一个生物标志物既具有绝对敏感又具有绝对特异性。因此,我们不能仅凭白细胞计数就做出诊断,还需要结合临床表现、相关实验室指标及影像学检查等结果。
总的来说,白细胞增多是一个复杂的临床现象,可能预示着多种健康问题。它可能是身体对抗感染的正常反应,也可能是某些严重疾病的信号。作为医生,我们需要全面考虑各种因素,谨慎解读这一指标,才能为患者提供准确的诊断和有效的治疗。